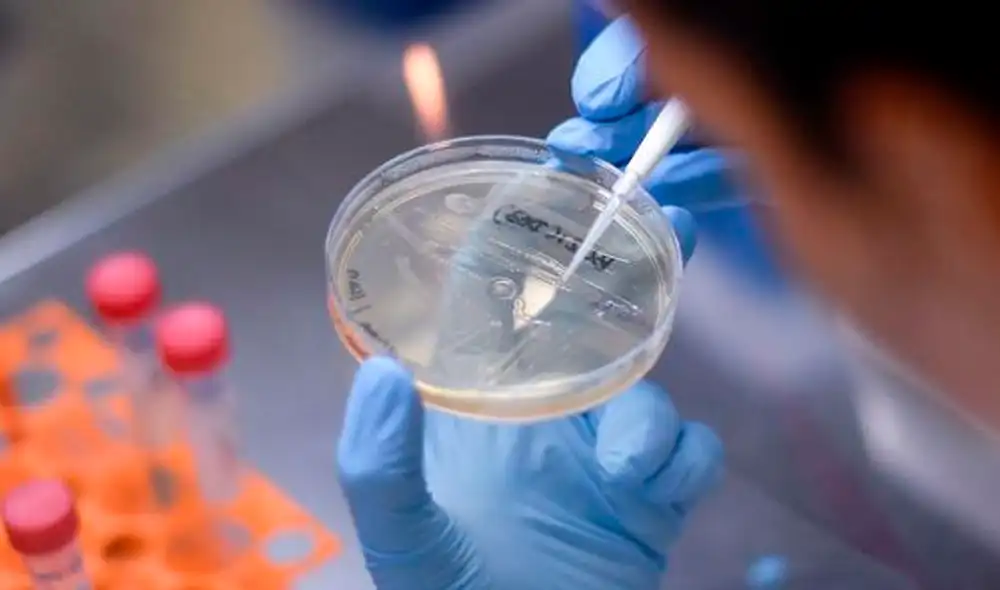
"Dados los riesgos para la salud pública de las vacunas inseguras o ineficaces, se necesita un liderazgo regulador", advierten los especialistas. Foto: EFE "Dados los riesgos para la salud pública de las vacunas inseguras o ineficaces, se necesita un liderazgo regulador", advierten los especialistas. Foto: EFE

“Puede ser fatal”: expertos advierten sobre autoexperimentación frente a la COVID-19
Los científicos exigen un liderazgo regulador ante el peligro de los remedios caseros que, presuntamente, garantizan una inmunidad contra el nuevo coronavirus.
- Los 10 apellidos más comunes en Venezuela: el primero de la lista es uno de los más populares en España
- Trump, Maduro y migración: Así se desarrolló el tenso debate entre Jara y Kast antes de las elecciones en Chile
Un conjunto de biólogos y médicos advierte sobre varias agrupaciones que trabajan para desarrollar y autoadministrarse antídotos no autorizados ni probados que describen como vacunas contra la COVID-19.
En un artículo publicado en la revista Science, los investigadores indican que, entre los actores que buscan tal propósito, se encuentran tanto colectivos como entusiastas independientes.
TE RECOMENDAMOS
MÁS PERUANOS CONTRA FUJIMORI: LO QUE SE LE VIENE A KEIKO | LA VERDAD A FONDO CON PEDRO SALINAS
PUEDES VER Criogenia: la hija de unos científicos lleva cinco años congelada a -196 ºC tras su muerte
Uno de ellos, explican los autores de la publicación es la asociación de científicos estadounidenses Colaboración para el Desarrollo Rápido de una Vacuna (RaDVaC, por sus siglas en inglés). En julio, el grupo informa haberse administrado una vacuna intranasal de elaboración propia que consiste de péptidos similares a los del SARS-CoV-2 y supuestamente asegura la inmunidad local al coronavirus.
Aunque la RaDVaC señala que considera su propósito como humanitario y que solo busca adelantar la omnipresencia de un antídoto contra la COVID-19, los procedimientos de esta asociación que opera en base a la ciencia ciudadana están lejos de los requeridos por los reglamentos. Así lo destacan los responsables del artículo.
“La ruta de investigación elegida por RaDVaC —que incluye una intervención casera, un protocolo en evolución y planes poco claros para recopilar y analizar los datos resultantes— contrasta con las rutas tradicionales para el desarrollo de vacunas que requieren ensayos controlados aleatorios (ECA) con criterios de valoración bien definidos como respuestas inmunes demostradas y protocolos relacionados con la retención y uso de datos”, sostienen.
PUEDES VER España: funcionario usa mascarilla para simular que habla inglés mientras otro pone la voz [VIDEO]
Formalmente, la Administración de Medicamentos y Alimentos de Estados Unidos (FDA, por sus siglas en inglés) no tiene jurisdicción con respecto a la elaboración de vacunas en casa y la difusión de datos sobre su creación; sin embargo, tiene el permiso de supervisar su transporte a través de las fronteras de estados.
“Dados los riesgos para la salud pública de las vacunas inseguras o ineficaces, se necesita un liderazgo regulador”, advierten los autores del escrito.
En un comentario publicado en un comunicado de la Universidad de Illinois, Jacob Sherkow, uno de los responsables de la publicación, insta a las personas a abstenerse de aplicarse remedios improvisados. “Todos simpatizamos con la idea de que la gente quiere vacunarse contra el virus. Pero la gente debe entender que no todos los remedios caseros ayudarán y algunos pueden ser fatales”, asegura el especialista.




















